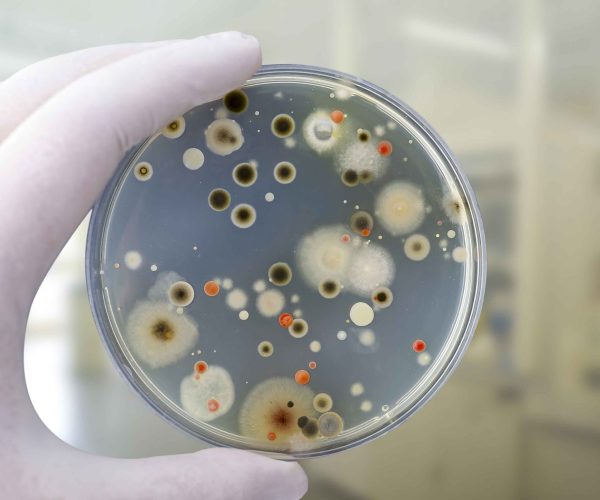
Environmental-Allergies-(Indoor) Environmental-Allergies-(Indoor)

What are Environmental Allergy tests?
These evaluate sensitivity to dust mites, mold spores, and cockroach allergens (pet dander is covered separately). Symptoms often persist year‑round and may worsen at night or in damp spaces.
What to expect during testing?
- Review of home/work environment (bedding, carpets, humidity, pests).
- Skin prick and/or blood IgE tests for key indoor allergens.
- Same‑day counseling on dust‑mite encasings, HEPA filtration, dehumidifiers (<50% humidity), and pest control if needed.